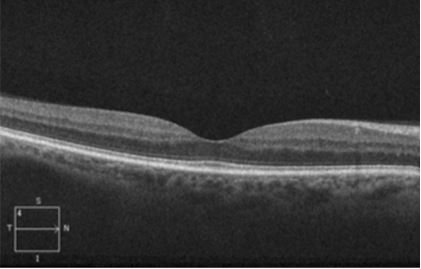

Ocular Coherence Tomography (OCT) scan of eye showing normal anatomy of the photoreceptor segments of retina. Image © E. Mitchel Opremcak, M.D., www.theretinagroup.com
Saturday, May 16, 2026
Welcome! Log into your account
Recover your password